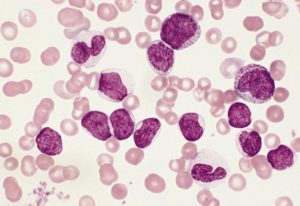
image
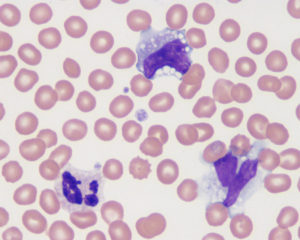
image
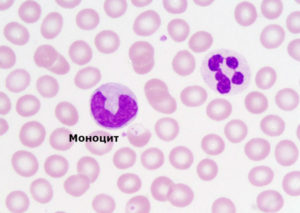
image

Почему в крови моноциты повышены, о чем это говорит?

Моноциты – зрелые, крупные лейкоциты, содержащие всего одно ядро. Данные клетки являются одними из наиболее активных фагоцитов, находящихся в периферической крови. Если анализ крови показал, что моноциты повышены – у вас моноцитоз, пониженный уровень называется моноцитопенией.
Моноциты кроме крови содержатся также в больших объемах в костном мозге, селезенке, синусах печени, стенках альвеол и лимфатических узлах. В крови они находятся недолго – всего несколько дней, после чего они перемещаются в окружающие ткани, где и достигают своей зрелости. Там происходит превращение моноцитов в гистоциты – тканевые макрофаги.
Количество моноцитов является одним из самых важных показателей при расшифровке анализа крови. У взрослых повышение количества моноцитов в общем анализе крови наблюдается при самых разных недугах, отдельно рассматриваются: инфекционные, гранулематозные и кожные заболевания, а также коллагенозы, к которым относится ревматоидный артрит, системная красная волчанка, узелковый полиартрит.
Роль моноцитов в организме
Для чего нужны моноциты, что это значит? Моноциты – белые кровяные клетки, лейкоциты, которые также относятся к фагоцитам. Это означает, что они поедают проникающие в организм микробы и бактерии и таким образом избавляются от них. Но не только.
В задачу моноцитов также входит очищение «поля битвы» от других погибших лейкоцитов, благодаря чему воспаление уменьшается, а ткани начинают регенерировать.Ну и, наконец, моноциты выполняют в организме еще одну важную функцию: они вырабатывают интерферон и предотвращают развитие всевозможных новообразований.
Важным показателем в крови является соотношение моноцитов и лейкоцитов. В норме процент моноцитов к всем лейкоцитам крови составляет от 4 до 12%.
Изменение этого соотношения в сторону увеличения в медицине носит название относительного моноцитоза. В отличие от этого случая возможен и рост общего числа моноцитов в крови человека.
Подобное патологическое состояние медики называют абсолютным моноцитозом.
Норма
Нормы моноцитов в крови немного отличаются для взрослых и детей.
- У ребенка норма моноцитов в анализе крови составляет примерно 2-7% от общего количества лейкоцитов. При этом необходимо учитывать, что абсолютное количество моноцитов у детей с возрастом изменяется, параллельно с изменением количества лейкоцитов.
- У взрослого нормальное количество моноцитов в крови составляет 1-8% от общего количества лейкоцитов. В абсолютных числах это 0,04-0,7*109/л.
Любые отклонения от нормы в количестве моноцитов в анализе крови может говорить про наличие в организме неполадок и заболеваний.
Причины повышенных моноцитов у взрослого
Если в крови повышены моноциты у взрослого, это значит наличие моноцитоза, который бывает относительным и абсолютным. При относительном характере моноцитоза в крови снижается уровень и других лейкоцитов, а при абсолютном — увеличивается лишь число моноцитов. Причиной повышения относительного содержания клеток крови может быть нейтропения или лимфоцитопения.
Повышенный уровень моноцитов в крови может говорить о наличии:
- Инфекционных процессов, вызванных бактериями (эндокардит, туберкулез, сифилис, малярия, бруцеллез, тиф), или вирусами (мононуклеоз, гепатит);
- Некоторых болезней кроветворной системы (в первую очередь – моноцитарный и миеломоноцитарный лейкоз);
- Некоторых вполне физиологических состояний (после еды, в конце месячных у женщин, у ребенка до 7 лет и т. д.);
- Попадания в организм (чаще в дыхательные пути) веществ неинфекционной (а часто и неорганической) природы;
- Злокачественных опухолевых заболеваний;
- Коллагенозов (системная красная волчанка – СКВ, ревматизм);
- Стадии выздоровления после инфекций и других острых состояний:
- Перенесенных хирургических операций.
Повышение уровня моноцитов в крови – тревожный симптом. Он может говорить о наличии в организме воспалительного процесса, иных серьезных заболеваний. Если общий анализ крови показывает уровень моноцитов выше нормы, необходима консультация врача и дополнительное обследование, чтобы выявить причину изменений.
Повышенные моноциты у ребенка
Что это значит? Появление моноцитоза у детей также часто связано с инфекциями, особенно, с вирусными. Как известно, дети вирусными инфекциями болеют чаще взрослых, и моноцитоз при этом говорит о том, что организм берется с инфекцией.
Моноцитоз у ребенка может появляться и при глистных инвазиях (аскаридозе, энтеробиозе и так далее), после того, как гельминты будут удалены из организма ребенка, моноцитоз проходит. Туберкулез у детей в настоящее время встречается редко, тем не менее, наличие моноцитоза должно настораживать и в этом отношении.
Также причиной могут быть онкологические заболевания у ребенка – лимфогранулематоз и лейкоз.
Что делать при повышенных моноцитах?
Когда моноциты в крови повышены, лечение зависит, в первую очередь, от причины этого явления. Конечно, легче вылечить моноцитоз, который возник из-за несерьезных заболеваний, например, грибка.
Однако когда речь идет о лейкозе или раковой опухоли, лечение будет повышенное содержание моноцитов в кровидлительным и тяжелым, прежде всего, направленным не на понижение уровня моноцитов, а на избавление от главных симптомов тяжелого заболевания.
(Visited 23 426 times, 29 visits today)
Моноциты: роль в организме, нормы и диагностика

Лейкоциты делятся на пять основных видов, каждый из которых имеет свои особенности во внешнем виде, строении и самое главное — каждый выполняет строго определённую функцию.
Это нейтрофилы, эозинофилы, базофилы, лимфоциты и моноциты.
Что такое моноциты и как они образуются
Стадии развития моноцита
Моноциты — это крупные и довольно красивые клетки, имеющие неправильную форму. Они как грозовые облака — пухлые, сероватые, с хорошо очерченным, но рыхлым по структуре единственным ядром.
Иногда ядро может принимать довольно причудливые формы (грецкого ореха, бабочки, гриба, подковы и др.), но в норме оно похоже на боб.
Расположено чаще всего не по центру и занимает половину или бо́льшую часть ядра.
Образуются моноциты в костном мозге из клеток промоноцитов. В кровоток они приходят незрелыми, циркулируют там 12 — 32 часа и затем часть из них погибает, а часть выходит в ткани. Чаще всего это лимфатические узлы, печень, лёгкие, селезёнка.
В тканях они дозревают окончательно, увеличиваются в размерах, иногда сливаются друг с другом, образуя гигантские формы. Там они живут ещё до 30 суток. Способны передвигаться к очагу воспаления или внедрения чужеродных объектов.
Синтезируют и секретируют различные активные вещества.
Определение уровня моноцитов в крови
Уровень моноцитов определяется с помощью общего анализа
Чтобы определить количество моноцитов, необходимо сдать кровь на общий анализ крови либо отдельно на лейкоцитарную формулу. Для этого можно брать венозную или периферическую кровь. Забор анализа производится с утра натощак. Накануне анализа не рекомендуется есть жирную пищу и принимать алкоголь.
Общий анализ крови производится на гематологическом анализаторе. Если количество моноцитов, их размер и строение нормальные, машина выдаст достоверный результат в процентах и абсолютное число моноцитов в 1 л крови. Если есть какие-то отклонения от нормы, будет стоять флажок и потребуется подсчёт глазами под микроскопом.
Из крови готовится мазок на стекле, который фиксируется и окрашивается специальным способом. После окраски стекло помещается под микроскоп. При окраске по Романовскому-Гимзе моноцит имеет окрашенную в светлый серовато-голубой цвет цитоплазму и яркое, малиново-красное, ядро.
В мазке моноциты значительно крупнее других элементов, хотя в капле крови они немногим крупнее других. Это связано с тем, что при изготовлении мазка моноциты более подвержены раздавливанию и распластыванию на стекле. Подсчитывается 200 лейкоцитов и процентное соотношение каждого вида.
Если имеются атипичные формы ядра, это тоже обязательно указывается.
Норма моноцитов в крови у взрослых
Нормальными референтными значениями принято считать от 3 до 9%. В некоторых источниках указывается — до 11%. Или 0,08 — 0,6 х 109/л — в абсолютных числах.
Причины увеличения моноцитов в крови
Гельминтоз как причина повышенных моноцитов
Моноцитоз бывает абсолютным, когда увеличивается именно количество клеток, и относительным, когда увеличение процентного соотношения идёт за счёт одновременного снижения количества других форм лейкоцитов.
Увеличение моноцитов в крови наблюдается при следующих заболеваниях:
- острые респираторные и другие вирусные заболевания;
- гельминтозные поражения организма (при энтеробиозе, тениозе, тениаринхозе, аскаридозе, описторхозе, фасциолёзе и т.п.);
- патологии крови — миеломная болезнь, острый миеломоноцитарный и моноцитарный лейкоз, миелобластный и монобластный лейкоз;
- злокачественные новообразования;
- отравления химическими веществами;
- аутоиммунные заболевания (системная красная волчанка, сахарный диабет первого типа, ревматоидный артрит, Базедова болезнь и другие);
- гранулематозные заболевания, такие как сифилис, туберкулёз, саркоидоз, бруцеллёз, энтерит и другие;
- цитомегаловирусная инфекция;
- такие заболевания, как корь, краснуха, коклюш, если человек не переболел ими в детстве;
- инфекционный мононуклеоз также характерен для детей, но изредка диагностируется и у взрослых.
У женщин во время беременности беременности и в первые дни месячных также можно наблюдать незначительное повышение моноцитов.
Причины снижения моноцитов в крови
Прием гормональных препаратов может вызывать моноцитопению
Моноцитопения, или снижение процентного сегмента моноцитов в крови ниже 1 встречается реже и наблюдается при следующих патологических состояниях:
- апластическая анемия;
- поздние стадии лейкозов;
- кожные инфекции (фурункулы, карбункулы и прочие);
- пневмония бактериального происхождения;
- сепсис;
- остеомиелит;
- острые инфекционные заболевания;
- приём цитостатиков и кортикостероидов.
При беременности и родах количество моноцитов также снижается.
О чем говорят повышенные моноциты у взрослого
Из этой статьи вы узнаете о чем это говорит, если у взрослого повышены моноциты. Моноциты обладают выраженной способностью к фагоцитозу (поглощению и уничтожению патогенных микроорганизмов). Поэтому их повышение закономерно связано с развитием инфекционного процесса в организме человека. Однако это не единственная возможная причина отклонения лабораторного параметра от нормы.
Основные функции моноцитов
По морфологии – это сравнительно крупные клетки, их диаметр достигает 20 мкм. Цитоплазма не содержит гранул, но в ней обнаруживается большое количество лизосом. Крупное ядро располагаетсяближе к одной из клеточных стенок. Оно не сегментировано и имеет бобовидную форму. Это позволяет легко дифференцировать моноциты от лимфоцитов при микроскопическом исследовании.
Несмотря на немногочисленность моноцитов крови здорового человека, переоценить их значение трудно.
В системном кровотоке они циркулируют не более 2 суток, а затем через стенку кровеносных сосудов диффундируют в межклеточное пространство.
Они начинают функционировать как полноценные макрофаги, уничтожая болезнетворные микроорганизмы. Кроме этого они способствуют очистке кровотока от погибших, опухолевых и мутантных клеток.
Поэтому повышенное содержание моноцитов– признак, указывающий на развитие патологического процесса. Знание точной причины позволяет подобрать оптимальное лечение.
Читайте далее: Что такое моноциты в анализе крови и их норма у женщин и мужчин по возрасту
Если моноциты повышены у взрослого, о чем это говорит?
В медицине подобное состояние описывается термином моноцитоз. Выделяют 2 формы:
- абсолютный моноцитоз, наблюдающийся при увеличении моноцитов и других лейкоцитарных клеток (моноцитов более 0.6 клеток на 109);
- относительный, когда увеличивается процентное содержание моноцитов относительно других субпопуляций лейкоцитов (более 11% моноцитов в анализе).
Диагностическая значимость относительной формы моноцитоза меньше, чем абсолютной.
Поэтому если в результатах анализа зафиксирован высокий процент моноцитов в крови, то исследование повторяется и подсчитывается абсолютное число клеток.
При каких болезнях повышаются моноциты у взрослых и детей?
Причины моноцитоза у взрослых напрямую зависят от выполняемых функций моноцитов. Клетки обладают способностью к выраженному фагоцитозу, а значит их большое количество необходимо при заражении инфекцией. Поэтому моноциты выше нормы обнаруживаются при острой стадии инфекции.
Моноциты способны уничтожать относительно большие по размеру отдельные клетки или скопление мелких частиц. В то время как нейтрофилы и эозинофильные гранулоциты фагоцитируют лишь мелкие чужеродные частицы, а затем сразу погибают.
После завершения фагоцитоза, моноциты не разрушаются и способны дальше осуществлять защитную функцию.
Основные заболевания
Примеры заболеваний, при которых обнаруживается повышение моноцитов в крови у женщин и мужчин:
- туберкулёз, основной орган поражения которого – лёгкие. Основная опасность болезни – возбудители (микобактерии) активно вырабатывают механизмы устойчивости ко всем известным группам антибиотиков. Кроме этого, патология характеризуется условно неблагоприятным исходом. Поэтому следует своевременно проходить флюорографию и сдавать лабораторные анализы;
- сифилис – венерическая инфекционная болезнь, распространение которой на территории РФ достигает критических значений. Исход при грамотном и своевременном лечении благоприятный. Однако если ребёнок был инфицирован в утробе, то у него происходят мутации, приводящие к дальнейшей инвалидности;
- саркоидоз;
- неспецифический язвенный колит – воспаление слизистой кишечника. Возникает в результате сочетанного проявления нескольких факторов: генетической предрасположенности, влияния окружающей среды и инфекционного заражения;
- эндокардит, когда инфекция поражает внутреннюю оболочку сердца. Условно неблагоприятный прогноз исхода обусловлен широкой распространённостью устойчивости бактерий к антибиотикам и высоким риском возникновения сердечной недостаточности. Часто болезнь сопровождается необратимыми патологическими изменениями клапанов сердца;
- инфекционный мононуклеоз;
- вирусные острые инфекции;
- грибковые инфекции;
- протозойные и риккетсиозные заражения;
- системные поражения соединительной ткани (коллагенозы);
- моноцитарные и миеломоноцитарные лейкозы и т.д.
Онкология
Еще одна причина повышенных моноцитов у взрослых – онкология. При этом злокачественный процесс затрагивает костный мозг, лимфатические узлы, органы пищеварения или мочеполовой системы.
Например, при множественной миеломной болезни происходит нарушение дифференциации лейкоцитов на стадии созревания в костном мозге.
Следует подчеркнуть, что изменение лабораторного показателя на ранних этапах может не обнаруживаться. Поэтому при подозрении на онкологическое заболевание проводится дополнительная диагностика: онкомаркеры, УЗИ, МРТ, а также другие лабораторные и инструментальные тесты.
Повышенный уровень моноцитов и базофилов фиксируется у людей с ревматоидными болезнями. Однозначная причина системного заболевания не установлена. Предполагается, что для развития артрита и узелкового периартериита у человека должна быть наследственная предрасположенность и сопутствующая хроническая инфекция.
Прогноз исхода для артрита и периартериита неблагоприятный. При этом артрит протекает медленно и осложнения при грамотной терапии наступают спустя длительное время. А узелковый периартериит развивается молниеносно с поражением сердечно-сосудистой, мочевыделительной и пищеварительной систем.
Столь серьёзные последствия и осложнения подчёркивают важность своевременной лабораторной диагностики и необходимость ежегодных профилактических осмотров.
Читайте далее: Все о базофилах — определение, нормы, причины отклонений
Беременность
Повышенные моноциты при беременности указывают на развитие патологического процесса, который может негативно сказаться на нормальном внутриутробном развитии ребёнка. Причины подобного состояния аналогичны: инфекционное заражение, онкология или ревматоидные заболевания.
Однако следует учитывать индивидуальные особенность каждой беременной пациентки. Во время вынашивания ребёнка не исключены гормональные сдвиги, избыточный стресс и изменения биохимического состава крови, повлекшие за собой активацию иммунитета. В результате этих процессов число моноцитов в крови повышается. При этом может изменяться как абсолютное их содержание, так и относительное.
Окончательное заключение о причинах превышения нормальных значений выносит лечащий врач после полной диагностики и сбора анамнеза.
Моноциты: что это такое, норма в крови, таблица по возрасту у женщин, мужчин, детей, за что отвечают в организме человека

Моноциты представляют группу лейкоцитов, не содержащих гранулы (агранулоциты). Они являются самыми крупными клетками крови.
Образуются моноциты в красном костном мозге и участвуют в формировании защитных реакций организма.
Что такое моноциты в организме человека и за что они отвечают?
Моноциты выходят в периферическую кровь и находятся в ней в течение 40 – 72 часов. Затем они мигрируют в органы и ткани для дальнейшего созревания, где происходит их трансформация в тканевые макрофаги.
Чтобы понять, в каких случаях наблюдается повышение или понижение моноцитов, является ли это патологией, нужно разобраться, что такое моноциты и какую функцию они выполняют.
Совокупность моноцитов и макрофагов с ретикулярными и эндотелиальными клетками образуют ретикулоэндотелиальную систему. Эта система осуществляет барьерную, фагоцитарную и метаболическую функции.
В зависимости от того, где находятся макрофаги, они приобретают определенные свойства. Различают следующие виды таких клеток:
- купферовские, образуются в результате миграции макрофагов в печень;
- литоральные, располагаются в лимфатических узлах и селезенке;
- костномозговые;
- микроглиальные, выстилают нервную ткань;
- перитонеальные, находятся в патологическом экссудате (жидкости, поступаемой в ткани при повышении проницаемости стенки сосудов);
- альвеолярные, находятся в ткани легких;
- остеокласты, располагаются в костях;
- гистиоциты, являются клетками соединительной ткани.
В первую очередь, следует разобраться, за что отвечают моноциты, от чего зависит их содержание в крови. Основной функцией этих клеток является защитная. Они участвуют в процессе фагоцитоза (внутриклеточного переваривания). Вначале фагоцит целенаправленно движется к вирусу, бактерии или поврежденной клетке.
Клетки крови – моноциты
Затем происходит адгезия (прилипание) чужеродного агента на поверхности макрофага. Это осуществляется за счет расположенных на фагоците специальных рецепторов или путем неспецифической адсорбции (поглощения). После этого активируются специальные лизосомальные ферменты, которые нейтрализуют или разрушают патогенный микроорганизм, находящийся внутри макрофага.
Моноциты принимают участие в формирование иммунного ответа. Макрофаги распознают чужеродный антиген, попавший в организм, и поглощают его.
Затем происходит расщепление этого антигена лизосомами, находящимися в цитоплазме моноцитов. Фрагменты расщепленного антигена образуют специальный комплекс, который выделяет особые вещества (интерлейкины).
В результате активизируются Т и В лимфоциты и образуются специфические к данным антигенам антитела.
Отвечая на вопрос, что такое моноциты в анализе крови, следует сказать, что они являются единственными клетками, которые вырабатывают тканевой тромбопластин. Это один из факторов свертывания крови, способствующий остановке кровотечений.
Не менее важной функцией макрофагов является их способность выделять активные вещества: простагландины, пирогенны, лизоцим, пропердин, интерферон.
Таким образом они участвуют в антибактериальной и противовирусной защите, регулируют клеточный и гуморальный иммунитет.
Как обозначаются в анализе крови?
При обращении в клинику доктор сначала направляет больного на сдачу клинических анализов. Результаты показателей пишутся латинскими буквами и имеют свои референсные значения. Поэтому самому пациенту сложно разобраться, как обозначаются моноциты в анализе крови, какое их значение является нормальным.
Доктор объяснит, что показывают моноциты в анализе крови, что это может обозначать, за что они отвечают у взрослого человека. В результатах анализов такой показатель записывается как MON. Этот результат может измеряться в процентном соотношении или в абсолютных единицах. Моноциты в крови в норме не превышают 11% от общего количества всех лейкоцитов.
Повышение этого показателя может быть относительным или абсолютным. Относительным называется увеличение процентного соотношения моноцитов больше нормы при их нормальном общем количестве. При этом число лейкоцитов в анализе крови остается в норме.
Относительный моноцитоз не имеет прогностического значения.
Абсолютным моноцитозом называется повышение их общего числа. Такое состояние обычно сопровождается одновременным увеличением других лейкоцитов.
Абсолютный моноцитоз – это явление патологическое и требующее дополнительного обследования для поиска причины.
Таким образом, на вопрос, о чем говорят моноциты в крови, можно ответить, что это показатель не неспецифичный. И трактовать его следует только в совокупности с другими лабораторными исследованиями. Почему могут быть понижены лейкоциты в крови?
Таблица норм моноцитов по возрасту
Нормы содержания моноцитов в крови у женщин, мужчин, детей (по возрасту) представлены в таблице.
| новорожденные | 3 — 12 | 0,19 -2,4 |
| До 2-х недель | 5-15 | 0,19 – 2,4 |
| До 1 года | 4 — 10 | 0,18 -1,85 |
| 1 – 2 года | 3 — 10 | 0,15 – 1, 75 |
| 2 – 3 года | 3-9 | 0,15 – 1, 75 |
| 3 – 7 лет | 3-9 | 0,12 – 1,5 |
| 7 – 10 лет | 3-9 | 0,10 – 1,25 |
| 10 лет – 16 лет | 3-9 | 0,09 – 1,15 |
| Девушки после 16 лет, женщины | 3-11 | 0,04 -0,8 |
| Юноши после 16 лет, мужчины | 3-11 | 0,04 -0,8 |
Таким образом, норма у взрослых мужчин и женщин не отличается. Количество моноцитов у детей в норме, указанное в таблице, наиболее высокое в первые недели жизни, а затем наблюдается постепенное снижение этого показателя.
У женщин
Нормы моноцитов у женщин по возрасту представлены в таблице выше. Чтобы не пропустить развитие тяжелых патологий, необходимо сдавать анализы крови минимум раз в год. А при наличии хронических заболеваний – через каждые 6 месяцев.
Норма моноцитов в крови у женщин не отличается от нормы у мужчин. Этот показатель у взрослых не имеет половых или возрастных различий.
У мужчин
Норма моноцитов у мужчин по возрасту указана в представленной выше таблице. Перед сдачей анализа крови запрещается употреблять пищу, приходить нужно строго натощак. Это необходимо для того, чтобы не было ложных результатов. У мужчин норма относительного и абсолютного содержания этих клеток такая же, как и у женщин.
Появление в общих анализах крови моноцитоза или моноцитопении не является самостоятельным диагнозом. Для уточнения и выявления причины такой патологии необходимо провести дополнительные инструментальные и лабораторные методы исследования.
Детей
У детей в норме в анализе крови моноциты в первые две недели жизни немного повышены и составляют 5-15 процентов. Затем их количество несколько уменьшается и практически не изменяется до конца жизни. Норма моноцитов в крови у детей после 16 лет составляет 3 – 11%, что соответствует таковой у взрослых.
Причины увеличения
Повышение количества моноцитов в крови принято называть моноцитозом.
Моноцитоз может наблюдаться при следующих состояниях:
- болезни крови: миелолейкоз, лимфома;
- бактериальные и вирусные заболевания;
- инфекционные болезни – бруцеллез, малярия, корь, ветрянка, дифтерия;
- злокачественные опухоли;
- острые инфекции в период реконвалесценции.
Повышение этого показателя у ребенка выше нормы чаще всего бывает при развитии инфекционного мононуклеоза. Это заболевание вызывается вирусом Эпштейна – Бара, в анализе при этой патологии также можно обнаружить и повышение количества лимфоцитов.
Почему могут снижаться?
Снижение количества моноцитов в крови (моноцитопению) могут вызывать:
- врожденный и приобретенный иммунодефицит;
- длительное лечение цитостатиками и кортикостероидами;
- опухоли костного мозга.
Также развитию подобного состояния может способствовать недостаток цианокобаламина и фолиевой кислоты, апластические или гипопластические анемии. На начальных стадиях при этих заболеваниях концентрация моноцитов может незначительно повышаться, но по мере дисфункции костного мозга наблюдается понижение их абсолютного количества.
Доктор Комаровский перечислит признаки инфекционного мононуклеоза и объяснит, почему это вирусное заболевание называют “поцелуйной болезнью” и каковы его признаки в анализе крови:
Заключение
- Моноциты участвуют в формировании специфического и неспецифического иммунитета и способствуют уничтожению патогенных клеток.
- Относительное повышение уровня моноцитов может наблюдаться в анализах крови после перенесенной острой вирусной инфекции.
- Абсолютное повышение моноцитов (их общего числа) является патологией. Больной в этом случае нуждается в назначении дополнительных методов исследования.
Причины повышения и понижения моноцитов в крови у взрослого
Так выглядит клетка моноцита (в центре) под микроскопом
Клетки моноциты — это ничто иное, как крупные лейкоциты. В первую очередь следует разобраться, за что отвечают клетки данного типа. Основные их функции заключаются в том, чтобы обеспечивать защиту человеческого организма от инородных клеток, очищая кровь от физических агентов. Моноциты имеют возможность поглощать не только части чужеродных микроорганизмов, но и их целиком.
Данные клетки находятся также в лимфоузлах и тканях, не только в крови.
Важно! Моноциты осуществляют очистку организма. Основной функцией данных клеток является создание определенных условий, при которых в тканях запускаются процессы регенерации. Такая функция активизируется, если ткани были повреждены чужеродными организмами, вследствие перенесенных воспалительных процессов и поражений, вследствие развития опухолей.
Каким должен быть их уровень?
Мы рассмотрели, что такое моноциты в анализе крови, теперь самое время разобрать, какой же их показатель является нормой. Поскольку данные клетки представляют собой один из видов лейкоцитов, то их измерение предполагает определение процента моноцитов в числе лейкоцитов.
Важно! Данный показатель абсолютно не зависит от половых или возрастных различий, а потому норма моноцитов у женщин и у мужчин находится на одном уровне. Есть лишь небольшие различия по возрасту и в определенные периоды у беременных.
Краткое видео о назначении и свойствах моноцитов
Нормальное содержание данных клеток следующее:
- В возрасте до 10 лет составляет от 2 до 12%.
- По достижении 12-летнего возраста — 3-10%.
Абсолютное содержание моноцитов — что это?
Таблица содержания всех форм лейкоцитов в крови
В случае с измерением моноцитов очень большую роль играет их абсолютное содержание в крови, а не только процентное. Дело в том, что общий анализ крови их количество определяет лишь относительно. Поэтому была разработана специальная методика для определения абсолютного содержания моноцитов в клетках одного литра крови.
Данный показатель записывается как «моноциты абс.» или Mon#. «Абс.» в данном случае и означает «абсолютный».
Моноциты абсолютные норма у взрослых составляет 0—0,08×109/л. У детей, не достигших 12 лет, данный показатель колеблется в пределах 0,05—1,1×109/л.
О чем свидетельствует повышенный уровень
Если моноциты повышены, то такое заболевание называется моноцитозом. Когда в крови повышенные моноциты, то это свидетельствует о присутствии чужеродных агентов в составе крови, что может указывать на развитие новообразований и инфекций.
Рассмотрим более подробно, что это значит — повышенные моноциты в крови. Данное явление может развиваться на фоне целого ряда заболеваний, потому такие признаки ни в коем случае нельзя игнорировать:
- Это может свидетельствовать о развитии туберкулеза.
Очень часто повышение моноцитов свидетельствует о развитии туберкулеза
- Возможны лимфома или лейкоз.
- Повышенный уровень моноцитов у взрослого может свидетельствовать о наличии заболеваний инфекционного характера в острой форме в стадии выздоровления. Это может быть корь, краснуха, мононуклеоз, дифтерия и т. д.
- Красная волчанка, ревматизм и т. д.
Важно! Аномальный уровень моноцитов в крови наблюдается при мононуклеозе. Это инфекционное заболевание крови очень часто поражает детей.
О чем свидетельствуют пониженные
Если моноциты понижены, диагностируется заболевание моноцитопения, на фоне которого может развиваться анемия и резко снижается уровень других кровяных элементов.
Фолиеводефицитная анемия и апластическая анемия — две наиболее распространенные причины падения уровня моноцитов. Также моноцитопения — это один из наиболее частых симптомов лечения препаратами глюкокортикоидного типа.
Нормальный (слева) и пониженный уровень моноцитов в крови
Важно! Если полностью отсутствуют в крови сегментоядерные моноциты, то это очень плохой признак. Чаще всего речь идет о тяжелой форме лейкоза, при которой продукция моноцитов останавливается. Также причиной может быть сепсис, когда для очистки крови недостаточно никаких количеств моноцитов и происходит разрушение кровяных клеток в результате воздействия токсинов.
Таким образом, серьезные проблемы со здоровьем могут возникать как при повышенном, так и при пониженном уровне моноцитов в организме. Поэтому при подозрении на какие-либо сбои в данном области необходимо немедленно обратиться к врачу.
Рекомендуем изучить похожие материалы:
- 1. Система гемостаза: зачем сдавать анализ на свёртываемость крови
- 2. Как подобрать диету по группе крови: худеем вместе
- 3. Причины и опасности повышения уровня базофилов у детей
- 4. Понизился уровень базофилов у взрослых: как лечить базофилию
- 5. Причины повышения или понижения нейтрофилов в анализе крови у детей?
- 6. Функции и возможные причины патологий сегментоядерных нейтрофилов
- 7. Нормы содержания нейтрофилов в крови и какие функции они выполняют
Что такое моноциты? Норма в анализе крови, причины повышения и понижения
Моноциты в анализе крови учитываются в составе лейкоцитарной формулы, занимая в норме от двух до десяти процентов общего количества лейкоцитарных клеток. В результатах анализа их отмечают в виде сокращения названия как MON.
Специфика моноцитов связана с активной борьбой с попавшими в организм вирусами. В связи с этим повышение моноцитов в крови свыше нормы однозначно указывает на то, что организм подключил иммунную систему к борьбе с каким-то вирусом.
С другой стороны, только по тому, что моноциты в крови повышены нельзя сразу же говорить о заболевании. Тем не менее вирусную основу изменения содержания моноцитов в крови следует иметь ввиду.
Конечно же однозначно сказать о том, что за вирус нет возможности. Для уточнения необходимо смотреть и другие результаты анализов или сделать дополнительные. В обычной жизни врачи знают эпидемиологическую обстановку в регионе и даже по этим данным можно с большой вероятностью сказать какой вирус “свирепствует” в регионе. Вот и появилась работа для моноцитов.
Что такое моноциты?
- Моноцит – крупнейшая клетка в циркулирующей крови (размером около 12-22 микрометров), она содержит большой объем цитоплазмы, которая окрашена в темно-серый цвет (часто называют “небо в день пасмурный”). Цитоплазма отличается мелкой азурофильной зернистостью, которая различима только при достаточной покраске мазка клетки.
- Ядро достаточно большое, обладает рыхлостью, полиморфностью, в виде трилистника, фасоли, подковы, встречается в виде такого насекомого, как бабочка с раскрытыми крыльями.
- Предшественница этих клеток (КОЕ-ГМ) единая с гранулоцитами, а сама предшественница именно моноцитарного ростка это КОЕ – М.
Эти клетки покидают костный мозг, так полностью не созрев, живут в кровяном русле около 20-40 часов, потом они покидают периферическую циркулирующую кровь и перемещаются в ткани, там они полностью специализируются.
- Покинув кровоток, клетки не смогут снова вернуться обратно.
Вышедшие в ткани моноциты становятся макрофагами (в некоторых органах имеют специфические названия, а именно: купферовские клетки печени, гистиоциты, содержащиеся в соединительной ткани, альвеолярные, плевральные макрофаги, остеокласты, микроглии нервной системы). В самих живых клетках органов они имеют возможность жить от месяца до многих лет.
- Движение моноцитов похоже на амебовидное, также они обладают фагоцитарной способностью. Переваривают не только собственные мертвые клетки, множество микроорганизмов и грибов, но и клетки, стареющие, такие как элементы крови, и зараженные вирусами.
- Они уничтожают за счет своих функций и строения очаг местного воспаления и создают условия для процесса репарации. Но в самом кровяном русле клетки почти не обладают своей фагоцитарной активностью.
- Помимо процесса фагоцитоза, моноциты обладают секреторной и синтетической способностями.
Они способны синтезировать и вырабатывать совокупность таких факторов, как «медиаторы» воспаления: интерферон-a, интерлейкины-1,-6, ФНО-α.
Здесь вы найдете интересную информацию про метамиелоциты в крови.
Как действуют моноциты?
Моноциты являются одним из наиболее важных элементов лейкоцитарной формулы, благодаря которой врач может своевременно выявить существующие нарушения.
При нарушениях количественного содержания моноцитов можно говорить о развитии внутренних нарушений.
Особое внимание необходимо уделять обследованию беременных женщин, поскольку в данный период иммунная система будущей мамы направляет все усилия на сохранение и нормальное развитие плода.
Моноциты обладают способностью к перемещению из кровяного русла к тканям организма. При этом моноцит изменит свою форму и трансформируется в макрофаг.
Трансформировавшийся моноцит может перемещаться к области очага воспаления для того, чтобы очистить воспаленную ткань от остатков клеток: лейкоцитарных, бактериальных, погибших.
Макрофаги создают оптимальные условия для того, чтобы были запущены восстановительные процессы в месте повреждения.
Активный моноцит способствует оказанию противоопухолевого, противомикробного, противовирусного, противопаразитарного иммунитета. Принимает участие в выработке фактора некроза опухоли, интерферона, интерлейкина, а также в процессе кровообразования и выработке специфической иммунной реакции.
Классификация и нормы
Для лечения моноцитоза важно диагностировать основную причину. В первую очередь рекомендуется консультация у врача, который сможет определить высокий уровень этих крупный лейкоцитов, и исходя из этого назначить терапию.
Изменения в образе жизни, регулярные упражнения, нормальный вес и адекватный сон, помогают контролировать количество этих лейкоцитов.
Также, потребление некоторых пищевых добавок и продуктов питания помогут нормализовать высокий уровень моноцитов.
Продукты питания
Продукты содержащие высокое количество антиоксидантов способствуют повышению иммунитета и снижению проникновения в организм патогенных (болезнетворных) микроорганизмов, вирусов.
Список продуктов питания и специй содержащие высокое количество антиоксидантов снижающие воспаления:
- Шпинат;
- Лук;
- Чеснок;
- Куркума;
- Черный тмин;
- Виноград;
- Черешня;
- Брокколи;
- Фасоль.
Диетические добавки
Добавка Омега-3 жирные кислоты включающие рыбий жир из печени трески, биологически активная добавка куркумина (куркуминоид, входящий в состав корня куркумы) помогают уменьшить воспаления и снизить количественное содержание моноцитов в крови.
Какую функцию выполняют моноцитарные клетки? Эти белые кровяные тельца группы лейкоцитов дополнительно относятся к фагоцитам, вырабатываются костным мозгом.
Выполняют защитную функцию путем поглощения попавших в организм микроорганизмов, очищения воспалительного поля от иных лизированных лейкоцитов, способствуя уменьшению воспалительного процесса и стимулированию регенерации окружающих очаг воспаления тканей организма. Еще одной задачей этих клеток выступает выработка интерферона и предотвращение онкообразований.
В норме моноцитарный показатель в отношении ко всем существующим лейкоцитам крови составляет в пределах 4-12 %.
1. У ребенка (девочка, мальчик) норма в анализе крови предусматривает около 2-7% от общего объема лейкоцитов. При этом надо учитывать, что абсолютная концентрация (процентное содержание) моноцитарных клеток у детей и у подростков с возрастом меняется, этот процесс изменяется параллельно с трансформацией показателей лейкоцитарной формулы.







